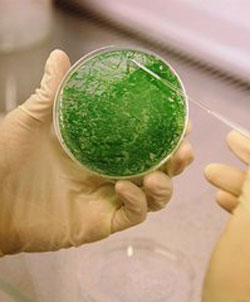

Noi invenţii biologice deschid o altă cutie a Pandorei
de Alex Ionescu
Motto: „Știința fără conștiință este ruina sufletului.”
François Rabelais
Dezastrul ecologic din golful Mexic din anul 2010
 La jumătatea anului 2010, mass-media americană semnala producerea unui dezastru ecologic în apele golfului Mexic datorită unor scurgeri masive de petrol la mare adâncime. Scurgerea de petrol a început pe 20 aprilie 2010, şi abia în luna iulie, după aproximativ trei luni, s-a reuşit închiderea rezervorului de petrol din adâncimea golfului Mexic.
La jumătatea anului 2010, mass-media americană semnala producerea unui dezastru ecologic în apele golfului Mexic datorită unor scurgeri masive de petrol la mare adâncime. Scurgerea de petrol a început pe 20 aprilie 2010, şi abia în luna iulie, după aproximativ trei luni, s-a reuşit închiderea rezervorului de petrol din adâncimea golfului Mexic.
Istoricul acestei probleme nu este foarte lung. Începând cu luna octombrie 2009 compania petrolieră British Petroleum (BP) începe să foreze în golful Mexic. Instalaţia de foraj este afectată în luna următoare de uraganul Ida. Lucrările continuă cu ajutorul companiei de foraj marin Deepwater Horizon, dar în februarie 2010 apar fenomene incontrolabile de tipul arderi de gaze şi rupturi ale planşeului rezervorului de petrol. După informarea autorităţilor de resort, BP închide puţul respectiv, dar a fost suficient timp pentru formarea unor lacuri de petrol la mare adâncime, în apele golfului Mexic. Dispersarea acestor lacuri, pentru a limita cât se poate de mult dezastrul ecologic, era o problemă foarte greu de rezolvat. Pentru a vă face o idee despre cantitatea de petrol care s-a scurs, amintim unele date care au circulat în lumea ştiinţifică în acea perioadă: s-a estimat că, în medie, se scurgeau aproximativ (10,1 ± 2,0) × 106 kg de petrol pe zi. O parte din acest petrol a afectat zona de coastă şi chiar nisipul plajelor din regiune.
În luna mai 2010, BP pulveriza cu asiduitate în golful Mexic Corexit – o substanţă care fragmentează petrolul în picături mici. Așa sunau declarațiile oficiale. Însă, ceea ce nu se afirma public este că la aceasta se adăugaseră substanţe minerale (cupru, fier, nichel, aluminiu etc.), care au fost depistate la analiza ulterioară a apei de ploaie din golf. Aceste metale constituiau de fapt „suplimente alimentare” pentru bacteriile mâncătoare de petrol care fuseseră folosite de BP în acțiunea de ecologizare a zonei.
În acea perioadă, celor care lucrau la îndepărtarea petelor de petrol din golful Mexic li s-a cerut să NU meargă la spitale publice pentru tratarea eventualelor probleme de sănătate. Această știre transmisă de CNN a stârnit un val de întrebări. Problemele medicale ale celor care lucrau acolo ar fi putut apărea în special datorită bacteriilor care trebuiau să consume ţiţeiul din apă. De ce nu se dorea ca afecțiunile determinate de aceşti microbi să fie analizate? Era ceva la mijloc care nu se voia să fie făcut public? Haideţi să vedem ce este cu aceste bacterii.
Synthetic Genomics
 Pe 13 iunie 2007, British Petroleum încheie un contract de cercetare-dezvoltare pe termen lung cu o companie numită Synthetic Genomics Inc. Valoarea investiţiei făcute de BP în acest contract nu a fost făcută publică. Cofondator la Synthetic Genomics era J. Craig Venter – cercetător care lucra de multă vreme în domeniul geneticii sintetice.
Pe 13 iunie 2007, British Petroleum încheie un contract de cercetare-dezvoltare pe termen lung cu o companie numită Synthetic Genomics Inc. Valoarea investiţiei făcute de BP în acest contract nu a fost făcută publică. Cofondator la Synthetic Genomics era J. Craig Venter – cercetător care lucra de multă vreme în domeniul geneticii sintetice.
J. C. Venter fondase cu mult timp înainte Institutul J. Craig Venter (IJCV), o companie non-profit axată pe cercetările în domeniul geneticii. La sfârşitul lunii mai 2007, IJCV a depus la forul pentru patente al SUA (US Patent) o aplicaţie care anunţa deţinerea exclusivă a unui set de gene esenţiale şi de „organisme sintetice libere care pot creşte şi se pot înmulţi”, care pot fi obţinute cu ajutorul acelor gene.
De ce ar încheia British Petroleum un contract cu Synthetic Genomics? Ce interes aveau petroliştii în genetică? Răspunsul este simplu: petrolul este un lichid extrem de vâscos, iar pentru a-l extrage în cantitate cât mai mare din pungile aflate în adâncime se folosesc diferite metode de fluidizare a lui, una dintre acestea fiind utilizarea de bacterii. Crearea de bacterii care să metabolizeze petrol a fost visul multor geneticieni. Microorganismele folosite la extragerea petrolului generează prin metabolizare subproduşi care fie propulsează petrolul în afară, fie creează substanţe de tip surfactanţi, care fac ca petrolul să alunece mai uşor. Procedeul poartă denumirea de recuperare crescută a petrolului cu ajutorul bacteriilor – MEOR (Microbial Enhanced Oil Recovery). Pentru un producător de petrol cum este BP, mai mult petrol şi gaze recuperate din punga de petrol descoperită se traduce în bani – mai mult profit. Cum era de aşteptat, o parte centrală a contractului între British Petroleum şi Synthetic Genomics era aceea de a crea unele bacterii, cu ADN făcut în laborator, care să îmbunătăţească curgerea de petrol şi gaze din rezervor.
Venter şi echipa sa au reuşit să producă o bacterie sintetică care a fost folosită de British Petroleum la extracţia ţiţeiului în golful Mexic. Problema era că forajul şi extragerea petrolului nu au mers aşa cum trebuia şi petrolul, împreună cu bacteriile respective, s-au răspândit în apă. De aceea se pulverizau cu asiduitate mineralele necesare pentru hrănirea bacteriilor, ca acestea să continue metabolizarea petrolului. Însă acţiunea acestor bacterii asupra omului nu era cunoscută, fiind posibile riscuri majore, întrucât atât petrolul, cât şi fiinţa umană sunt alcătuite din substanțe pe bază de carbon, iar aceşti microbi erau creaţi pentru a mânca hidrocarburi. Deci, cu alte cuvinte, era foarte posibil ca bacteriile să înceapă să mănânce ţesuturi umane, să producă leziuni incontrolabile la cei care lucrau pentru evacuarea pungilor de petrol. Practic, comportamentul acestor bacterii sintetice odată scăpate în mediu nu era cunoscut, nu putea fi estimată capacitatea lor de a se transmite de la o persoană la alta, dacă afectează ființele umane sau cât de grave pot fi leziunile pe care le determină, cum anume pot fi tratate eventualele boli pe care le produc. BP avea toate motivele să fie foarte îngrijorată. De aici și interdicția impusă lucrătorilor din golf de a se prezenta la unitățile medicale publice – un gest incalificabil, cu dublă semnificație: de a limita răspândirea unor eventuale boli impredictibile, produse de bacteriile sintetice dar, totodată, de a proteja imaginea și interesele financiare ale BP, cât și secretele companiei, care și-a permis să utilizeze în exploatarea petrolului metode insuficient testate, ale căror riscuri sunt incalculabile.
O scurtă incursiune în istoria creării bacteriilor sintetice. Synthia.
 Cu toate progresele înregistrate de știință, crearea în laborator chiar și a unui organism minuscul, așa cum este o bacterie, care să aibă ADN sintetic şi să prezinte anumite proprietăţi, nu este deloc simplă. Au fost necesari treizeci de ani de teste şi experimente pentru a se reuşi sinteza, asamblarea, clonarea şi transplantul unui cod genetic sintetic, „confecţionat” în laborator din substanţe chimice, într-o celulă care ulterior va funcţiona după acest cod genetic.
Cu toate progresele înregistrate de știință, crearea în laborator chiar și a unui organism minuscul, așa cum este o bacterie, care să aibă ADN sintetic şi să prezinte anumite proprietăţi, nu este deloc simplă. Au fost necesari treizeci de ani de teste şi experimente pentru a se reuşi sinteza, asamblarea, clonarea şi transplantul unui cod genetic sintetic, „confecţionat” în laborator din substanţe chimice, într-o celulă care ulterior va funcţiona după acest cod genetic.
În toate laboratoarele de cercetare în domeniul ingineriei genetice, eforturile de a înţelege şi manipula informaţia codată în ADN a întâmpinat numeroase dificultăți. Chiar dacă s-a reuşit descifrarea anumitor secvenţe genice la multe specii, inclusiv la om, la ora actuală pentru niciuna din specii nu se cunoaşte în totalitate la ce servesc toate genele codului genetic respectiv. Natura, înzestrată cu o înțelepciune proprie, nu a lăsat omul care nu are deschiderea spirituală necesară să îi descopere toate secretele. Viața rămâne un mister fascinant ce nu poate fi închis într-un tipar materialist – mecanicist.
În 1995, Venter şi echipa sa au decodificat genomul Mycoplasmei genitalium, bacteria cu cel mai mic număr de gene dintre toate organismele capabile de creştere independentă în laborator. Apoi, după cum se ştie oficial, timp de 15 ani (până în 2010), ei au urmărit să creeze o bacterie sintetică, folosind peretele bacterian al Mycoplasmei capricolum şi un genom sintetizat chimic în laborator după un model realizat pe computer, pornind de la genomul Mycoplasmei mycoides. Noile bacterii obţinute s-au dovedit capabile de autoînmulţire continuă. Codul genetic al acestora nu prezintă ADN natural. Această nouă formă de viaţă se poate înmulţi şi se dezvoltă în orice celulă ajunge, preluând controlul acesteia. Deci… un mic robot bacterian confecţionat în laborator. În plus, s-a observat că în genomul sintetic al bacteriei create s-au introdus şi gene de rezistenţă la antibiotice, care fac ca în cazul unei infecții apărute la om, tratamentul să fie extrem de dificil.
Pe 15 mai 2010, J. Craig Venter, ca reprezentant al Institutului J. C. Venter a dat publicităţii un anunţ referitor la crearea în laborator a primului microb sintetic, o celulă bacteriană care consumă hidrocarburi mai eficient decât orice microorganism natural. Bacteria a fost denumită „synthetic Mycoplasma mycoides JCVI – syn1.0”. Grupul ETC din Canada, care se ocupă de investigarea problemelor socioeconomice şi ecologice care apar ca urmare a utilizării de noi tehnologii, a numit această bacterie Synthia. În mass-media ea a fost denumită de multe ori Cynthia. Până la data respectivului anunț, IJCV făcuse deja cereri pentru mai multe patente de astfel de bacterii sintetice.
Venter nu a precizat dacă a făcut studii de securitate privind interacţiunea acestei bacterii cu celule sau ţesuturi de provenienţă umană. Dacă ne gândim la interdicția de a nu se prezenta la unitățile medicale publice pentru tratarea eventualelor probleme de sănătate, ce a fost impusă celor care lucrau la îndepărtarea lacurilor de petrol din Golful Mexic în 2010, cel mai probabil astfel de studii nu au fost făcute, sau rezultatele lor erau îngrijorătoare și nu trebuiau date în niciun caz publicității.
Într-un articol publicat în revista Science, Terry Hazen şi colegii săi de la Laboratorul Naţional Lawrence Berkeley informează că au descoperit o specie anterior necunoscută de bacterie de apă rece (o referire elegantă la bacteria confecţionată în laborator!) ce mănâncă hidrocarburi, ce a fost introdusă la sfârşitul lunii mai şi începutul lunii iunie 2010, în pungile de petrol din adâncimea golfului Mexic pentru degradarea acestora cu viteze mai mari.
Într-un interviu radio realizat de Rick Wells la True News la sfârşitul lunii iunie 2010, expertul în industrie petrolieră Matt Simmons, întrebat de ce guvernul SUA nu se implică în criza din golf, a spus că „British Petroleum susţine că este singura care deţine tehnologia care să rezolve asta”.
Nebunia alianţei British Petroleum – Synthetic Genomics continuă
 În mod evident, zona în care existau pungile de petrol la mare adâncime nu putea fi izolată de restul oceanului. Astfel că, atât uraganele, cât şi curenţii marini, puteau împrăştia bacteria sintetică în toată lumea. BP trebuia deci să găsească o modalitate de control al acestei probleme. Una din posibilităţi era crearea unui vaccin sintetic care să neutralizeze efectele bacteriei.
În mod evident, zona în care existau pungile de petrol la mare adâncime nu putea fi izolată de restul oceanului. Astfel că, atât uraganele, cât şi curenţii marini, puteau împrăştia bacteria sintetică în toată lumea. BP trebuia deci să găsească o modalitate de control al acestei probleme. Una din posibilităţi era crearea unui vaccin sintetic care să neutralizeze efectele bacteriei.
Pe 7 octombrie 2010, Synthetic Genomics Inc. şi Institutul J. C. Venter (IJCV) au anunţat formarea unei noi companii – Synthetic Genomics Vaccines Inc. (SGVI). Atât timp cât manevrarea informaţiei genetice din diferitele microorganisme a ajuns un fel de Lego de copii pentru Venter şi echipa sa, de ce să nu mai înfiinţeze o instituţie pentru un alt scop, dar care să folosească aceleaşi tehnologii în domeniul genetic? Aşa cum se spunea la infiinţarea Syntethic Genomics Vaccines, compania privată avea drept scop dezvoltarea următoarelor generaţii de vaccinuri folosind experienţa bogată în ceea ce priveşte sinteza de coduri genetice a IJCV şi ingeniozitatea comercială a Synthetic Genomics Inc.
Se pare că este foarte profitabil nu numai să creezi bacterii sintetice dar, de asemenea, să oferi un vaccin în caz că apar probleme. Când creezi bacteria şi controlezi ADN-ul ei, ştii de asemenea cum să îl anulezi. „Suntem emoţionaţi să aplicăm tehnologiile avansate de sinteză genomică pentru a revoluţiona producţia de vaccin”, a spus Fernanda Gandara, preşedinte SGVI.
Reacţii
ETC Group, o organizaţie internaţională civilă cu sediul la Ottawa, Canada, avertiza că biologia de sinteză este un domeniu de mare risc prin care se urmăreşte în primul rând profitul economic. Formele de viaţă create în laborator pot scăpa de sub control şi pot constitui amenințări la adresa întregii planete și a umanității sau, în mâinilor unor psihopați (inclusiv guverne), pot deveni arme biologice. „Cel mai îngrijorător aspect dintre toate este acela că Craig Venter mânuieşte această tehnologie puternică în industria cea mai iresponsabilă şi devastatoare pentru mediul înconjurător, prin asocierea cu cei ca BP (…), pentru accelerarea comercializării de forme de viaţă sintetice”, avertiza ETC Group.
Dr. Venter şi colegii colaborează deja cu companii farmaceutice şi de combustibili, pentru design şi producere de cromozomi pentru bacterii care ar produce vaccinuri sintetice şi combustibili de interes.
Dr. Helen Wallace de la Genewatch UK, o organizaţie care monitorizează dezvoltarea tehnologiilor genetice, a avertizat la rândul său, într-un interviu pentru BBC News, asupra pericolului pe care bacteriile sintetice îl pot reprezenta. „Dacă eliberezi noi organisme în mediu, poţi face mai mult rău decât bine. (…) Prin eliberarea lor în arii poluate (cu scopul de a le curăţa, n.a.), de fapt eliberezi o nouă formă de poluare. (…) Nu ştim cum vor reacţiona aceste organisme în mediu.” Dr. Wallace l-a acuzat pe dr. Venter că a minimalizat potenţialele consecinţe ale utilizării bacteriilor sintetice. „Nu este Dumnezeu”, a afirmat Wallace, „este de fapt foarte om; încearcă să scoată banii investiţi în tehnologia lui şi să evite reglementările care i-ar restricţiona utilizarea bacteriilor.”
Câteva concluzii…
Prin urmare, cercetătorii orbiţi de orgoliu au ajuns să creeze „roboţi” bacterieni, fără să fie interesați prea mult de consecințele dramatice pe care „creaţiile” respective le-ar putea avea asupra oamenilor și aupra mediului înconjurător. Cu toate că sunt departe de a înțelege la ce sunt de folos toate genele unei specii, expediază ceea ce nu au descifrat ca fiind un balast inutil și folosesc doar genele care aparent se ştie ce fac. Practic, iau câteva gene de aici, altele de colo și creează în laborator coduri genetice sintetice, care să corespundă scopurilor pe care le urmăresc. În această joacă inconștientă de-a ucenicul vrăjitor nu se gândesc nicio clipă că sunt total desprinşi de armonia ecosistemelor naturale şi că „operele” lor pot face foarte mult rău.
Prin urmare, cercetătorii orbiţi de orgoliu au ajuns să creeze „roboţi” bacterieni, fără să fie interesați prea mult de consecințele dramatice pe care „creaţiile” respective le-ar putea avea asupra oamenilor și aupra mediului înconjurător. Cu toate că sunt departe de a înțelege la ce sunt de folos toate genele unei specii, expediază ceea ce nu au descifrat ca fiind un balast inutil și folosesc doar genele care aparent se ştie ce fac. Practic, iau câteva gene de aici, altele de colo și creează în laborator coduri genetice sintetice, care să corespundă scopurilor pe care le urmăresc. În această joacă inconștientă de-a ucenicul vrăjitor nu se gândesc nicio clipă că sunt total desprinşi de armonia ecosistemelor naturale şi că „operele” lor pot face foarte mult rău.
Și în acest domeniu extrem de sensibil, ce își permite cu multă trufie să manipuleze chiar viața, ceea ce primează sunt interesele financiare și faima. Dacă ar fi fost altfel, cercetătorii nu ar fi petrecut 30 de ani chinuidu-se se creeze o bacterie după cum cred ei de cuviință, ci ar s-ar fi străduit mai degrabă să descifreze semnificația genelor care deocamdată sunt necunoscute.
Bacteriile sintetice reprezintă ceva mai mult în domeniul manipulărilor genetice decât organismele modificate genetic. În cazul OMG se alterează un cod genetic deja existent, natural, prin introducerea unor gene care codifică anumite substanțe, în timp ce la bacteriile sintetice codul genetic este în totalitate făcut de mâna omului!
Venter și echipa lui de cercetători a deschis o cutie a Pandorei din care deocamdată nu ştim ce va mai ieşi. Sperăm, totuşi, ca această muncă de pionierat în domeniul roboţilor biologici confecţionaţi de om să se oprească până nu este prea târziu şi cercetarea ştiinţifică în toate domeniile să se facă cu adevărat pentru binele tuturor fiinţelor umane, nu doar pentru beneficiile financiare ale câtorva.
Bibliografie:
Creation of a Bacterial Cell Controlled by a Chemically Synthesized Genome, Daniel G. Gibson, John I. Glass, Carole Lartigue, Vladimir N. Noskov, Ray-Yuan Chuang, Mikkel A. Algire, Gwynedd A. Benders, Michael G. Montague, Li Ma, Monzia M. Moodie, Chuck Merryman, Sanjay Vashee, Radha Krishnakumar, Nacyra Assad-Garcia, Cynthia Andrews-Pfannkoch, Evgeniya A. Denisova, Lei Young, Zhi-Qing Qi, Thomas H. Segall-Shapiro, Christopher H. Calvey, Prashanth P. Parmar, Clyde A. Hutchison III, Hamilton O. Smith, J. Craig Venter – Science 2 July 2010, Vol. 329 no. 5987 pp. 52-56,
Synthetic Genome Brings New Life to Bacterium, Elizabeth Pennisi – Science 21 May 2010, Vol. 328 no. 5981 pp. 958-959,
Deep-Sea Oil Plume Enriches Indigenous Oil-Degrading Bacteria, Terry C. Hazen, Eric A. Dubinsky, Todd Z. DeSantis, Gary L. Andersen, Yvette M. Piceno, Navjeet Singh, Janet K. Jansson, Alexander Probst, Sharon E. Borglin, Julian L. Fortney, William T. Stringfellow, Markus Bill, Mark E. Conrad, Lauren M. Tom, Krystle L. Chavarria, Thana R. Alusi, Regina Lamendella, Dominique C. Joyner, Chelsea Spier, Jacob Baelum, Manfred Auer, Marcin L. Zemla, Romy Chakraborty, Eric L. Sonnenthal, Patrik D’haeseleer, Hoi-Ying N. Holman, Shariff Osman, Zhenmei Lu, Joy D. Van Nostrand, Ye Deng, Jizhong Zhou, Olivia U. Mason – Science 8 October 2010, Vol. 330 no. 6001 pp. 204-208,
Applications of science and engineering to quantify and control the Deepwater Horizon oil spill, Marcia K. McNutt, Steven Chu, Jane Lubchenco, Tom Hunter, Gabrielle Dreyfus, Steven A. Murawski, and David M. Kennedy – Proc. Natl. Acad. Sci. USA 11 December 2012: 20222-20228,
Chemical data quantify Deepwater Horizon hydrocarbon flow rate and environmental distribution, Thomas B. Ryerson, Richard Camilli, John D. Kessler, Elizabeth B. Kujawinski, Christopher M. Reddy, David L. Valentine, Elliot Atlas, Donald R. Blake, Joost de Gouw, Simone Meinardi, David D. Parrish, Jeff Peischl, Jeffrey S. Seewald, and Carsten Warneke – Proc. Natl. Acad. Sci. USA 11 December 2012: 20246-20253,
Hydrocarbon-Degrading Bacteria and the Bacterial Community Response in Gulf of Mexico Beach Sands Impacted by the Deepwater Horizon Oil Spill, Joel E. Kostka,Om Prakash, Will A. Overholt, Stefan J. Green, Gina Freyer, Andy Canion, Jonathan Delgardio, Nikita Norton, Terry C. Hazen and Markus Huettel – Appl. Environ. Microbiol. 15 November 2011: 7962-7974,
The BP/Synthetic Genomics Project: The Gulf Blue Plague, Michael Edward, December 23, 2010
Citiți și:
Corporaţia americană Monsanto vrea să deţină controlul mondial asupra hranei, impunând forţat pe piaţa de consum, organismele modificate genetic
Codex Alimentarius – un evident și cutremurător genocid planetar deghizat
yogaeosteric
23 mai 2014
